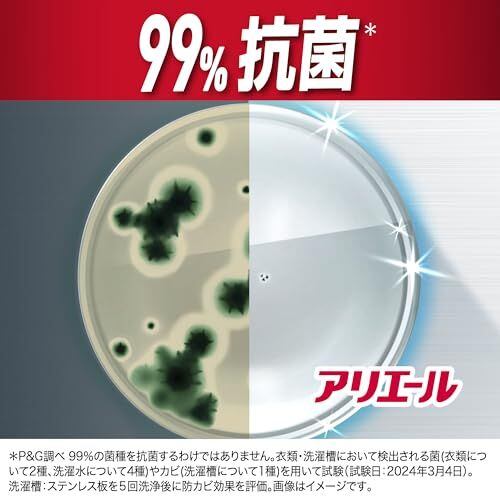

アリエール 洗濯洗剤 液体 超抗菌プレミアム 部屋干し超消臭 天日干し級にさわやかな香り 詰め替え 625gx6袋 [ケース品]
¥2,414
残り1点
International shipping available
99%抗菌+防カビ。衣類・洗濯水・洗濯槽防カビ 洗濯洗剤 *99%の菌種を抗菌するわけではありません。衣類・洗濯槽において検出される菌(衣類について2種、洗濯水について4種)やカビ(洗濯槽について1種)を用いて試験。カビは除去しません。
部屋干し&スポーツ漂白剤レベル消臭* *当社液体洗剤と25年5月時点の酸素系液体漂白剤の併用での比較(P&G調べ)。ニオイの度合いにより、消臭の程度は異なります。漂白剤は洗濯機直投入の条件でテスト。
部屋干しぎゅうぎゅうでも消臭* スポーツ着用中の汗臭も消臭* *P&G調べ。ニオイの度合いで消臭の程度は異なります。
天日干し級にさわやかな香り
エコならアリエール超抗菌プレミアム eco 再生可能電力を一部使用した工場で生産されています* *パッケージを除く
長持ち濃縮タイプ 液体洗剤
すすぎ1回OK!タテ・ドラム式対応。自動投入洗濯機にも。
NEW 部屋まで!まるごと消臭!*1 最高レベルの抗菌成分*2 18時間抗菌*3 干した衣服も部屋もW消臭!*1 厚手タオルやパーカーの生乾き臭も徹底消臭*1 洗濯サイクルエンドレス消臭!脱ぐ瞬間までニオイ断つ!*1 洗濯槽の防カビ*4 10%濃縮!*5 少ない量で同じだけ洗える 縦型・ドラム式・すすぎ1回OK *1 P&G調べ。ニオイの度合いで消臭の程度は異なります。 *2 アリエール超抗菌プレミアムシリーズにおいて。 *3 全ての菌の増殖を抑えるわけではありません。 *4 カビは除去しません。 *5 2023年のアリエール超抗菌プレミアムシリーズ比。 アリエール 洗濯洗剤 液体 超抗菌プレミアム 部屋干し超消臭
界面活性剤(23%:直鎖アルキルベンゼンスルホン酸塩、ポリオキシエチレンアルキルエーテル)、安定化剤、分散剤、pH調整剤、蛍光増白剤、酵素